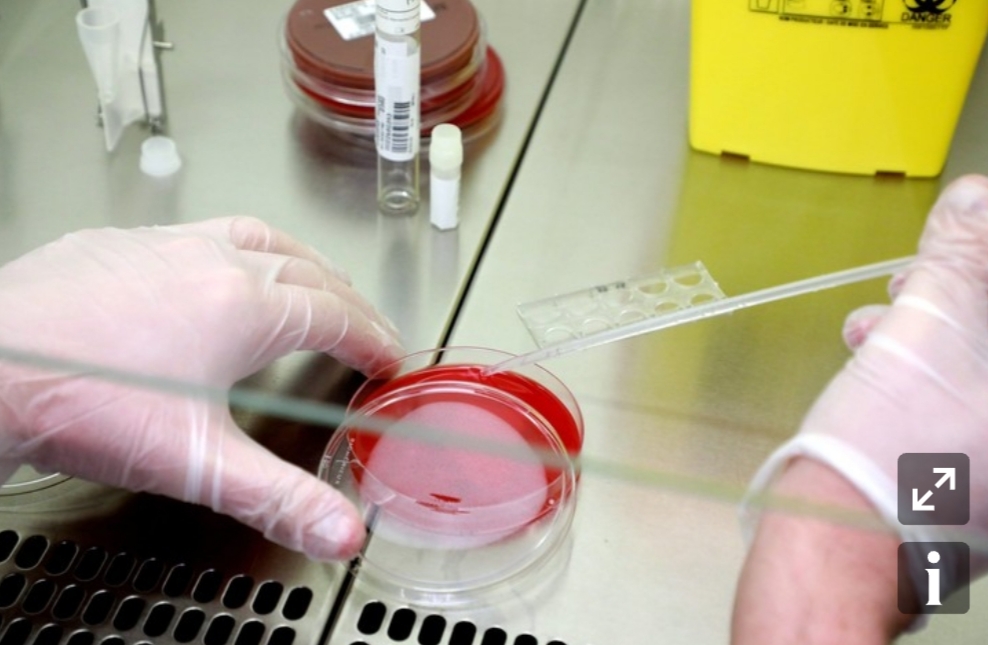
...

Des chercheurs chinois ont annoncé qu’un médicament antipaludéen, la chloroquine, serait efficace chez des malades infectés par le nouveau coronavirus Covis-19. Toutefois, encore trop préliminaire, cette étude ne convainc ni les spécialistes ni le ministère français de la santé.
« C’est probablement le traitement le moins cher et le plus simple pour traiter le coronavirus Covid-19», a estimé, enthousiaste, mardi 25 février Didier Raoult, directeur de l’Institut hospitalo-universitaire Méditerranée infection à Marseille, sur France Info. Il évoquait un essai clinique mené dans une dizaine d’hôpitaux chinois pour mesurer « l’efficacité de la chloroquine sur le traitement de pneumonies associées au Covid-19 » et publié en ligne le 19 février 2020 dans une revue (1). Menée sur « plus de 100 patients », cette étude aurait donné des résultats encourageants.
Dans ce traitement expérimental mené dans plus de dix hôpitaux chinois (Wuhan, Pékin, Shanghaï…), « les résultats obtenus jusqu’à présent ont montré que le phosphate de chloroquine était plus efficace que le traitement reçu par le groupe comparatif pour contenir l’évolution de la pneumonie, améliorer l’état des poumons, pour que le patient redevienne négatif au virus, et pour raccourcir la durée de la maladie », précisent les chercheurs chinois qui, cependant, ne publient aucun chiffre pour quantifier cette différence d’efficacité.
Jusqu’ici, la chloroquine était une molécule essentiellement utilisée pour sa capacité à prévenir et traiter le paludisme (ou malaria). En France, elle a été mise sur le marché dès 1949 sous le nom de Nivaquine. C’est un dérivé de la quinine, un alcaloïde naturel antipaludique, extrait de l’écorce du quinquina, un arbuste d’Amérique du Sud connu des indigènes péruviens pour sa capacité à faire baisser la fièvre.
Les médecins chinois avaient, semble-t-il, prouvé l’efficacité de la chloroquine sur le Sras (syndrome respiratoire aigu sévère) qui avait fait 774 morts dans le monde en 2003. Autre avantage de la chloroquine selon Didier Raoult : « C’est un traitement qui ne coûte rien, 500 mg de chloroquine par jour pendant 10 jours, à raison de 10 centimes le comprimé. »
► Un résultat très préliminaire à prendre avec prudence
Très enthousiastes, les propos de Didier Raoult sont cependant tempérés par d’autres chercheurs et cliniciens dont Yazdan Yazdanpanah, immunologiste à l’Inserm et à l’hôpital Bichat, un des deux hôpitaux parisiens qui a accueilli les premiers patients atteints par le coronavirus, ou François Maignen, pharmacologue et spécialiste de santé publique, qui appartient au collectif « FakeMed », qui veut lutter contre les fausses informations en santé.
« Il faut être extrêmement circonspect et prudent, et avoir à disposition les protocoles, pour savoir comment l’étude a été conduite, quels ont été les critères d’évaluation, la population de patients », selon les standards habituels de tests de médicaments, explique-t-il. « La chloroquine qui n’a pas fait la preuve de son efficacité clinique contre le coronavirus peut entraîner des effets indésirables graves », remarque-t-il, comme des affections du système immunitaire, affections gastro-intestinales, nausées, vomissements, des troubles au niveau hépatique voire hématologique. La chloroquine peut même être « très dangereuse en cas de surdosage », ajoute-t-il, alertant en outre contre le risque de développement de résistance à la chloroquine.
« Aucune étude rigoureuse, publiée dans une revue internationale à comité de lecture indépendant, ne démontre l’efficacité de la #chloroquine (Nivaquine) pour lutter contre l’infection au #CoronavirusFrance chez l’être humain », a même tweeté le ministère de la santé dans une publication intitulée « Désinfox ».
Plusieurs molécules sont en tout cas actuellement testées pour lutter contre le nouveau virus. « Il existe beaucoup de molécules pharmacologiques qui ont accès aux virus, qui réussissent à entrer à l’intérieur et à perturber leur métabolisme jusqu’à, sinon les tuer, du moins bloquer leur action ou leur reproduction, explique François Moutou, vétérinaire et ancien épidémiologiste à l’Anses. Ce n’était pas forcément prévu par les pharmacologistes qui ont conçu la molécule dans leur laboratoire, mais cela peut s’avérer efficace. Mais, dans cette étude, l’échantillon de patients est faible et on ne dispose pas d’informations sur les conditions opératoires. On ne sait pas par exemple si les malades n’ont reçu que de la chloroquine, et pas autre chose en même temps. »
LA GAZETTE avec (la-croix.com/France )
Category
- Log in to post comments













